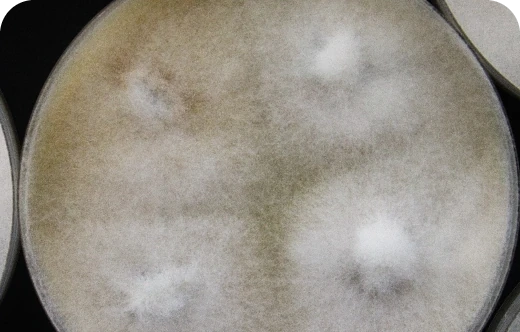
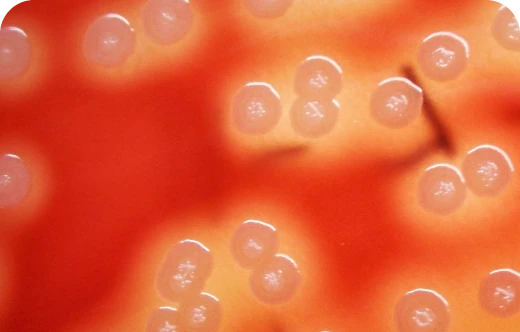
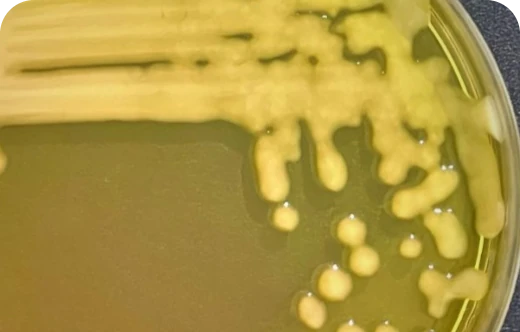
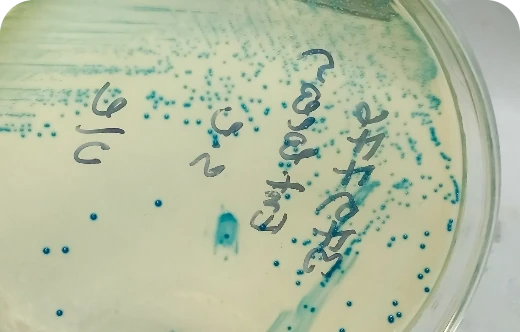
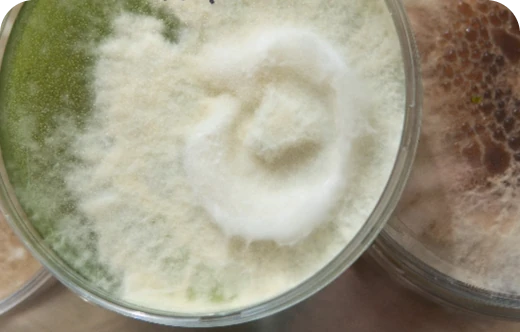

pioneira na produção de Macro-organismos no RS
hectares com a Tecnologia On Farm
atendidos no Rio Grande do Sul
A GoBio é especialista em soluções biológicas para agricultura e carrega o propósito de produzir e distribuir macro e micro-organismos para efetuar o controle de pragas e doenças em lavouras.
Fundada em 2016, pela Dra. Gabriela Alles, a empresa está concluindo uma década de sucesso, atendendo a clientes em todo o Rio Grande do Sul e realizando a proteção de mais de 50 mil hectares.
Soluções para revolucionar a agricultura moderna com inovação e sustentabilidade.
Uso de inimigos naturais para gerenciar pragas agrícolas de maneira sustentável e eficaz.

Inseto parasitóide Trichogramma pretiosum. Registro no MAPA 29418. Importante ferramenta para o Manejo Integrado de Pragas (MIP) de lepidópteros. Parasitóide de ovos de lepidópteros visando o controle de várias espécies de lagartas.

Ácaro predador Neoseiulus barkeri. Registro no MAPA 18921. Ácaro predador generalista que se alimenta de vários tipos de pragas, como ácaro rajado, tripes, ácaro branco, ácaro do enfezamento do morango, etc.

Inseto parasitóide Neochrysocharis formosa. Registro no MAPA 17721. Produto eficiente no controle das moscas-minadoras do gênero Liriomyza, eliminando-as em sua fase larval e usando-as para se reproduzir (parasitismo) e também como alimento (predação).

Inseto predador Chrysoperla externa. Registro no MAPA 02222. Um dos melhores agentes biológicos utilizados em diversas culturas para controle de diferentes tipos de pragas. Também é chamado popularmente de bicho lixeiro ou crisopídeo.

Parasitóide Telenomus podisi. Registro no MAPA 32120. Uma das principais ferramentas para o controle biológico de percevejos na cultura da soja. Telenomus podisi é uma microvespa que se desenvolve dentro dos ovos do percevejo hospedeiro, matando esse ovo e impedindo a emergência de ninfas da praga.
Uso de fungos e bactérias como agentes naturais de controle de doenças e pragas agrícolas.

Controle de doenças de solo e foliares, promotor de crescimento e enraizamento.

Bionematicida e fungicida de solo e foliar, promotor de crescimento e enraizamento.
Promove germinação uniforme do sulco, atua como enraizador e fixa o nitrogênio.
Combate doenças foliares, como mofo branco e ferrugem.
Importante bactéria extraída de um cactus. Reduz estresse hídrico.
Solubilizador de fósforo, promotor de crescimento e enraizamento.
Fungos formadores de micorrizas. Formam uma simbiose com a raiz da planta ampliando até 3m para cada centímetro de raiz.

Tecnologia de multiplicação de fungos e bactérias agrícolas para uso no controle biológico.

Acompanhamos todo o processo do cultivo, desde a preparação do solo até a colheita, com conhecimento técnico para garantir o sucesso da sua lavoura de maneira mais sustentável.
Conte com a nossa equipe para entender as necessidades do seu cultivo e tornar sua produção mais eficiente, rentável e amiga do meio ambiente.
Com a GoBio, você impulsiona o crescimento da sua lavoura, do início ao fim.
Ajudamos a tornar a sua colheita melhor, mais lucrativa e mais sustentável.
Possibilidade de tornar o produto orgânico e elevar a produtividade.
Redução de resíduos químicos e tóxicos no solo, na água e nos alimentos.
Maior rentabilidade no uso da terra.
Regeneração do solo e proteção da biodiversidade.
Por serem inimigos naturais, pragas e doenças não desenvolvem resistência.
Confira quem ajuda a tornar nosso trabalho ainda melhor.


Conheça as tecnologias biológicas da GoBio.
Podemos ajudar o seu negócio. Envie a sua mensagem e nós responderemos em breve.